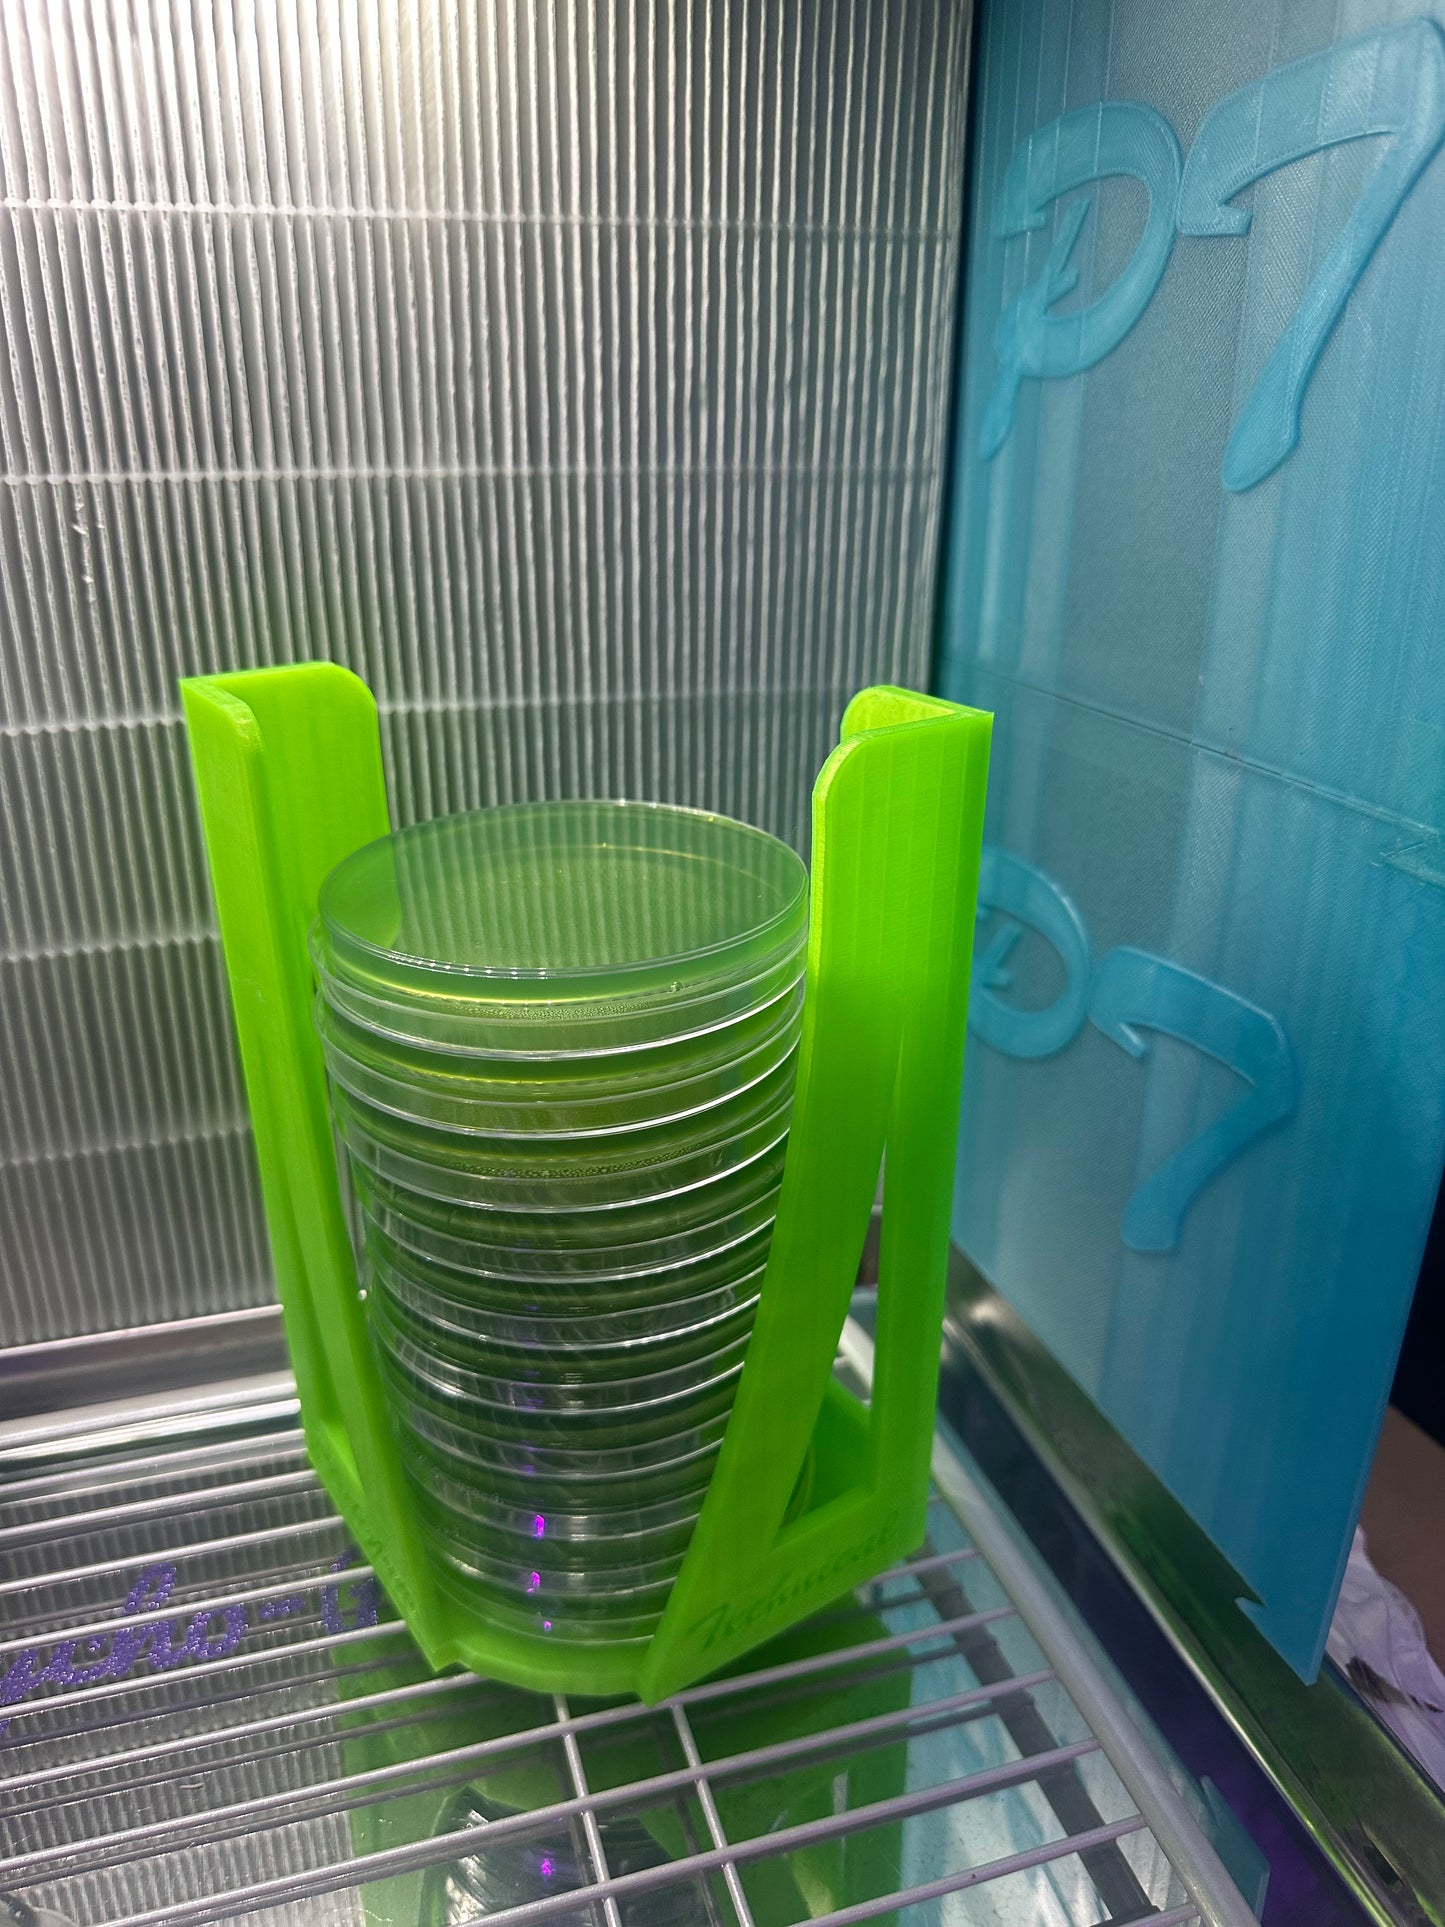

PsychoPlaty
🍄 Psycho Platy’s Custom Agar Plate Holders 🍄
🍄 Psycho Platy’s Custom Agar Plate Holders 🍄
5.0 / 5.0
(1) 1 total reviews
Couldn't load pickup availability
🍄 Psycho Platy’s Custom Agar Plate Holders 🍄
Alright, spore slingers—listen up. If you’re tired of your precious agar plates toppling over like a clumsy chimp, I’ve cooked up something to bring a little order to your mad science.
These beauties are my custom 3D-printed plate holders, forged in the depths of the mycelial laboratory.
🌀 Why You Need ‘Em:
🔹 Chaos-Proof Stability: No more stacks sliding onto the floor—these holders keep your plates upright and locked in place.
🔹 Colour-Coded for Sanity: Red, blue, green…whatever helps you remember which plates are your gourmet clones and which ones are brewing mutant nightmares.
🔹 Built Tough: Designed to survive your most hectic agar sessions.
🔹 Slick & Compact: Tuck them into your SAB, flow hood, or shelf without hogging precious space.
🔹 Capacity: Holds about 10–12 plates (standard 90–100mm)—enough for a real grower to get busy.
Claim yours and level up your cultivation lair—because sloppy stacks are for amateurs.
(Agar plates not included—obviously.)
Share